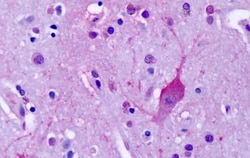
Invitrogen mGluR4 Polyclonal Antibody 50 &mu;g; Unconjugated:Anticuerpos

missing translation for 'onlineSavingsMsg'
Learn More
Learn More
Invitrogen™ mGluR4 Polyclonal Antibody


Descripción
Percent identity with other species by BLAST analysis: Human, Chimpanzee, Gorilla, Gibbon, Monkey, Mouse, Rabbit, Pig (100%) Rat, Hamster, Dog (94%) Horse, Opossum (88%).
The Metabotropic Glutamate Receptor mGluR4/GRM4 binds L-glutamate, the major excitatory neurotransmitter in the central nervous system, which activates both ionotropic and metabotropic glutamate receptors. Glutamatergic neurotransmission is involved in most aspects of normal brain function and can be perturbed in many neuropathologic conditions. The metabotropic glutamate receptors are a family of G protein-coupled receptors that have been divided into 3 groups on the basis of sequence homology, putative signal transduction mechanisms, and pharmacologic properties.

Especificaciones
Especificaciones
| Antígeno | mGluR4 |
| Aplicaciones | Immunohistochemistry (Paraffin), Western Blot |
| Clasificación | Polyclonal |
| Concentración | 1 mg/mL |
| Conjugado | Unconjugated |
| Formulación | PBS with 0.1% sodium azide |
| génica | GRM4 |
| N.º de referencia del gen | Q14833, Q68EF4 |
| Alias de gen | G protein-coupled receptor GRM4; G protein-coupled receptor, family C, group 1, member D; glutamate metabotropic receptor 4; glutamate receptor; glutamate receptor, metabotropic 4; GPRC1D; GRM4; Metabotropic glutamate receptor 4; mGlu4; MGLUR4 |
| Símbolos de los genes | GRM4 |
| Mostrar más |
Título del producto
Al hacer clic en Enviar, acepta que Fisher Scientific se ponga en contacto con usted en relación con los comentarios que ha proporcionado en este formulario. No compartiremos su información para ningún otro fin. Toda la información de contacto proporcionada se mantendrá de acuerdo con nuestra Política de Privacidad. Política de privacidad.
¿Detecta una oportunidad de mejora?